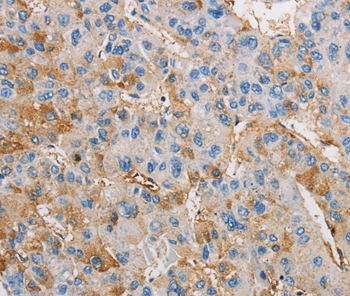
Anti-DIRAS3 Antibody

Immunohistochemical staining of human breast shows strong membranous positivity in glandular cells.
Anti-DIRAS3 Antibody
HPA028483
ApplicationsWestern Blot, ImmunoHistoChemistry
Product group Antibodies
ReactivityHuman
TargetDIRAS3
Overview
- SupplierAtlas Antibodies
- Product NameAnti-DIRAS3 Antibody
- Delivery Days Customer4
- ApplicationsWestern Blot, ImmunoHistoChemistry
- CertificationResearch Use Only
- ClonalityPolyclonal
- ConjugateUnconjugated
- Gene ID9077
- Target nameDIRAS3
- Target descriptionDIRAS family GTPase 3
- Target synonymsARHI, NOEY2, GTP-binding protein Di-Ras3, DIRAS family, GTP-binding RAS-like 3, distinct subgroup of the Ras family member 3, ras homolog gene family, member I, rho-related GTP-binding protein RhoI
- HostRabbit
- IsotypeIgG
- Protein IDO95661
- Protein NameGTP-binding protein Di-Ras3
- Scientific DescriptionRecombinant Protein Epitope Signature Tag (PrEST) antigen sequence
- ReactivityHuman
- Storage Instruction-20°C,2°C to 8°C
- UNSPSC41116161